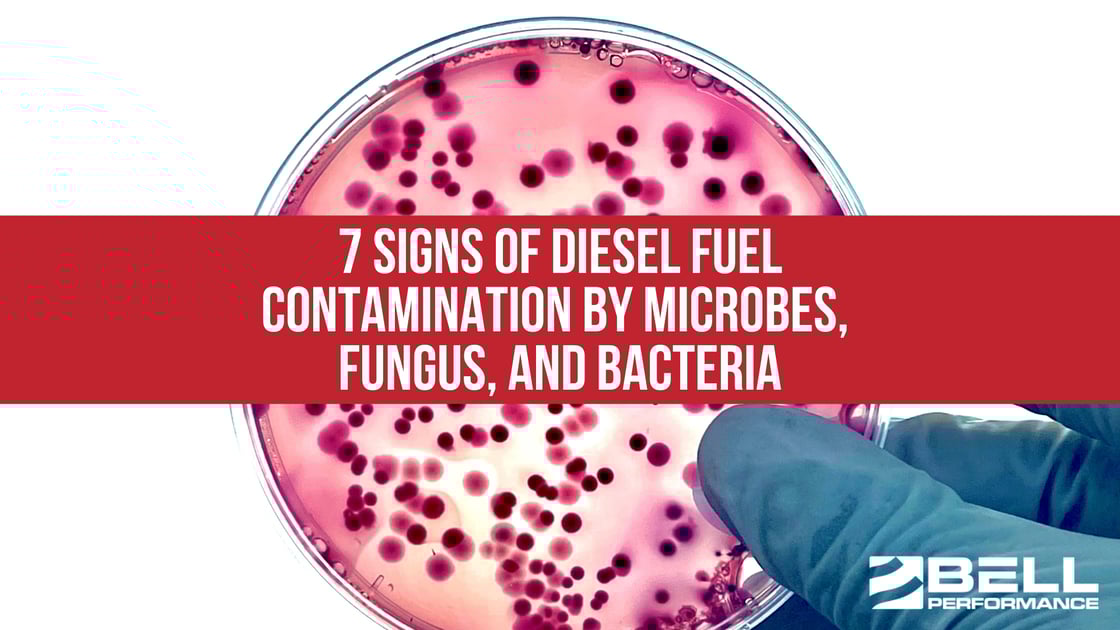
7 Signs of Diesel Fuel Contamination by Microbes, Fungus, and Bacteria

1 min read
How Long Does Diesel Last In A Tank?
For hospitals maintaining emergency generators, utilities protecting grid stability, data centers ensuring uptime, and fleets managing fuel...
3 min read
Bell Performance : Oct 21 2025
Maintaining today's stored backup fuels is a bigger job than it used to be. One major reason is that fuels themselves have changed. Ultra-low sulfur diesel (ULSD) has less natural stability and lubricity, while biodiesel blends tend to absorb and hold more water. On top of that, modern storage systems often create conditions that trap small amounts of water at the bottom of tanks (and which may be all microbes need to start contamination). All of this makes today’s stored fuels far more vulnerable to microbial growth than the fuels of years past.
Given this, you're much more likely to encounter water and microbial growth problems in the essential emergency fuels that generators, hospitals, and municipalities rely on. In fact, you could say it's virtually inevitable that stored fuel today will, eventually, develop microbial contamination.
Do you have reason to suspect you’re running on diesel or biodiesel contaminated by microbes, bacteria, and fungus? Here are some signs to look for which can give you a pretty good idea:
Some of these problems are more commonly seen in fleets and vehicle situations while others are seen to a greater extent in fuel storage and backup generator systems. But any of these symptoms can indicate a microbial infestation, whether in your storage tank or the place where you get your fuel from. Microbial contamination is now the biggest cause of fuel problems in stored fuels.
The best way to prevent microbial diesel fuel contamination is to control tank water buildup. Bell Performance Dee-Zol and DFS Plus are formulated to do this. But even the best housekeeping methods can fail sometimes, especially if not everyone in the supply chain is doing the same thing. Once you have a microbial problem, the only way to permanently end it is to kill it with a biocide like Bell Performance Bellicide. Controlling water is important, but as microbes don't need very much water present to grow and thrive, the chances are much higher that, at some point in your system's professional service life, you're going to have to deal with microbial contamination problems.
Lastly, the upstream oil and gas market has taught us the utility of microbial testing. Testing is the third arm of the Hybrid Approach to Fuel Care - chemical, mechanical, testing - that is the best practice for taking care of stored fuel.
Testing is the diagnostic arm - it gives you the benefit of a clearly defined problem so you don't have to solely rely on inferences from what you notice. There are lots of tests you can do, so you'll want to consider which tests are best for you in terms of showing you the real condition of your fuel (descriptive) alongside giving you a window into anticipating whether its condition is going to change (predictive).
Descriptive tests may include water and sediment or water by Karl Fischer. Recommended predictive tests definitely include the stability tests like D2274 (oxidative stability).
If your system is in the "mission critical" category, it may also be worth your while to consider upgrading to some kind of periodic microbial testing of fuel samples from your system. In-field microbial testings like ATP-By-Filtration can give you a much clearer picture of whether you have microbial contamination (and how much), as well as being an invaluable tool to show if the problem has been solved.
Today's reality is that microbial contamination is no longer a “maybe”—it’s a “when.” Even the best housekeeping practices can’t guarantee your system will stay clean forever. That’s why the most reliable strategies combine prevention, treatment, and verification.
If your operation is mission critical—whether that means a hospital, data center, or municipal emergency system—this isn’t optional. The cost of inaction can be catastrophic. By taking a proactive, hybrid approach, you protect your fuel, your equipment, and the people who rely on you when it matters most.
Do you have any other experiences? Feel free to comment and let us know.
1 min read
For hospitals maintaining emergency generators, utilities protecting grid stability, data centers ensuring uptime, and fleets managing fuel...

1 min read
The concept of preventive maintenance isn't new—we see it everywhere in our daily lives. You change your car's oil before it breaks down. You...
1 min read
Service companies working with government installations, hospitals, data centers, and emergency response facilities - the places we call "mission...